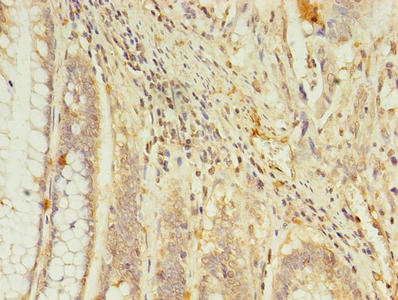

RGS7 Antibody
-
中文名稱:RGS7兔多克隆抗體
-
貨號:CSB-PA019659LA01HU
-
規格:¥440
-
圖片:
-
其他:
產品詳情
-
產品名稱:Rabbit anti-Homo sapiens (Human) RGS7 Polyclonal antibody
-
Uniprot No.:
-
基因名:RGS7
-
別名:RGS7 antibody; Regulator of G-protein signaling 7 antibody; RGS7 antibody
-
宿主:Rabbit
-
反應種屬:Human
-
免疫原:Recombinant Human Regulator of G-protein signaling 7 protein (1-487AA)
-
免疫原種屬:Homo sapiens (Human)
-
標記方式:Non-conjugated
本頁面中的產品,RGS7 Antibody (CSB-PA019659LA01HU),的標記方式是Non-conjugated。對于RGS7 Antibody,我們還提供其他標記。見下表:
-
克隆類型:Polyclonal
-
抗體亞型:IgG
-
純化方式:>95%, Protein G purified
-
濃度:It differs from different batches. Please contact us to confirm it.
-
保存緩沖液:Preservative: 0.03% Proclin 300
Constituents: 50% Glycerol, 0.01M PBS, PH 7.4 -
產品提供形式:Liquid
-
應用范圍:ELISA, IHC
-
推薦稀釋比:
Application Recommended Dilution IHC 1:20-1:200 -
Protocols:
-
儲存條件:Upon receipt, store at -20°C or -80°C. Avoid repeated freeze.
-
貨期:Basically, we can dispatch the products out in 1-3 working days after receiving your orders. Delivery time maybe differs from different purchasing way or location, please kindly consult your local distributors for specific delivery time.
-
用途:For Research Use Only. Not for use in diagnostic or therapeutic procedures.
相關產品
靶點詳情
-
功能:Regulates G protein-coupled receptor signaling cascades. Inhibits signal transduction by increasing the GTPase activity of G protein alpha subunits, thereby driving them into their inactive GDP-bound form. The RGS7/GNB5 dimer enhances GNAO1 GTPase activity. May play a role in synaptic vesicle exocytosis. Modulates the activity of potassium channels that are activated by GNAO1 in response to muscarinic acetylcholine receptor M2/CHRM2 signaling.
-
基因功能參考文獻:
- Results found that RGS7 was mutated in 11% of melanomas with three recurrent mutations (p.R44C, p.E383K and p.R416Q). p.R44C was shown to destabilize the protein due to the loss of an H-bond and salt bridge. RGS7 p.R44C has weaker catalytic activity for its substrate Galphao, thus providing a dual mechanism for its loss of function resulting in increase anchorage-independent growth, migration and invasion of melanoma c... PMID: 29330521
- Data (including data from studies using transgenic mice) suggest that R7BP-RGS7 heterotrimers interact with Galpha13 to augment signaling pathways in neurons that regulate neurite morphogenesis. (R7BP = RGS7 family binding protein; RGS7 = regulator of G-protein signaling 7 protein; Galpha13 = GTP-binding protein alpha subunit 13) PMID: 28432124
- R7-binding protein had a strong inhibitory effect on homo-oligomerization of RGS7. PMID: 26895961
- Fine mapping of the uterine leiomyoma locus on 1q43 close to a lncRNA in the RGS7-FH interval PMID: 26113603
- New single nucleotide polymorphisms associated with differences in platelets reactivity in patients with type 2 diabetes treated with acetylsalicylic acid: genome-wide association approach and pooled DNA strategy. PMID: 23054467
- the GAP activity of RGS9-2 showed a strong receptor preference for D2R over MOR. Finally, RGS7 displayed an four times greater GAP activity relative to RGS9-2. PMID: 23857581
- Gi/o signaling and the palmitoyltransferase DHHC2 regulate palmitate cycling and shuttling of RGS7 family-binding protein. PMID: 21343290
- tumor necrosis factor-alpha regulates the interaction of RGS7 with 14-3-3 PMID: 12077120
- could play a role in synaptic vesicle exocytosis through its interaction with snapin PMID: 12659861
- Galpha-regulated plasma membrane localization and palmitoylation of RGS7. PMID: 15496508
- cytoplasmic RGS7*Gbeta5*R7BP heterotrimers and RGS7*Gbeta5 heterodimers are equivalently inefficient regulators of G protein-coupled receptor signaling relative to plasma membrane-bound heterotrimers bearing palmitoylated R7BP. PMID: 16867977
- The DEP domain of RGS7 can directly bind to the third intracellular loop of the M3R and attenuate receptor-induced Ca2+ mobilization in a M3 subtype-selective manner. PMID: 19182865
- cytosolic chaperonin complex-dependent mechanism exists for Gbeta5-RGS7 assembly that utilizes the co-chaperone activity of PhLP1 in a unique way PMID: 19376773
- common variation within the RGS7 locus may be involved in multiple sclerosis susceptibility. PMID: 19626040
顯示更多
收起更多
-
亞細胞定位:Cytoplasm, cytosol. Cytoplasm. Cell membrane. Membrane; Peripheral membrane protein; Cytoplasmic side.
-
數據庫鏈接:
Most popular with customers
-
-
YWHAB Recombinant Monoclonal Antibody
Applications: ELISA, WB, IHC, IF, FC
Species Reactivity: Human, Mouse, Rat
-
Phospho-YAP1 (S127) Recombinant Monoclonal Antibody
Applications: ELISA, WB, IHC
Species Reactivity: Human
-
-
-
-
-